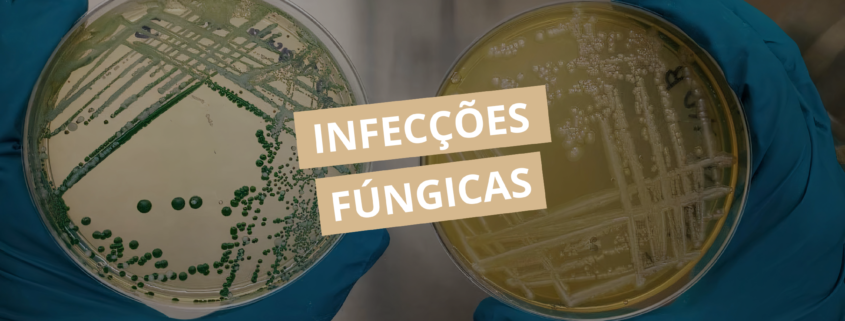

Infecções Fúngicas
As infecções fúngicas representam um desafio relevante na prática clínica e laboratorial, variando de manifestações superficiais, como dermatofitoses, a quadros sistêmicos graves, como candidemias e aspergiloses invasivas. Causadas por fungos patogênicos oportunistas ou primários, essas infecções exigem diagnóstico preciso e manejo adequado para garantir eficácia terapêutica e reduzir complicações.
O estudo dessas infecções na microbiologia clínica é essencial para a identificação do agente, determinação de susceptibilidade e monitoramento do tratamento, contribuindo para decisões clínicas seguras e fundamentadas. Além disso, o avanço das técnicas laboratoriais, incluindo métodos moleculares e análises automatizadas, vem ampliando a capacidade de detectar infecções de forma precoce e confiável.
Classificação das infecções fúngicas
As infecções fúngicas podem ser classificadas de acordo com a profundidade e gravidade do acometimento:
- Superficiais: atingem pele, cabelos e unhas, sendo geralmente autolimitadas ou de fácil manejo. Exemplos incluem tinea corporis, tinea capitis e onicomicose. Apesar de não serem normalmente graves, essas infecções podem causar desconforto significativo e afetar a qualidade de vida.
- Subcutâneas: envolvem tecidos mais profundos e costumam surgir após traumatismos que permitem a inoculação direta do fungo. Exemplos são esporotricose e micetoma, que frequentemente exigem acompanhamento clínico prolongado e tratamento antifúngico específico.
- Sistêmicas ou invasivas: acometem órgãos internos e podem ser potencialmente fatais, especialmente em pacientes imunocomprometidos. Entre elas destacam-se candidemia, aspergilose invasiva e criptococose. Essas infecções demandam diagnósticos rápidos e precisos, bem como intervenções terapêuticas intensivas.
Essa classificação não apenas orienta o manejo clínico, mas também guia as estratégias laboratoriais para detecção e confirmação do agente causador.
Principais agentes fúngicos
Entre os principais agentes fúngicos de importância clínica estão:
- Candida spp.: responsável por infecções mucosas e sistêmicas. É o fungo mais prevalente em infecções hospitalares, podendo colonizar correntes sanguíneas, trato urinário e mucosas.
- Aspergillus spp.: geralmente relacionado a infecções respiratórias e invasivas, especialmente em indivíduos imunossuprimidos. A inalação de esporos é a forma mais comum de infecção, que pode evoluir para aspergilose pulmonar ou disseminada.
- Cryptococcus spp.: destacadamente em pacientes com imunossupressão, sendo a criptococose meningea uma das formas mais graves.
- Dermatophytes (Trichophyton, Microsporum, Epidermophyton): fungos queratinofílicos que causam infecções cutâneas e de anexos, como unhas e cabelos.
- Fungos emergentes (Fusarium, Scedosporium): geralmente resistentes a antifúngicos convencionais, podem causar infecções graves e disseminadas em ambientes hospitalares e comunitários.
A diversidade desses agentes exige que os laboratórios clínicos possuam métodos variados e especializados para identificar corretamente cada espécie, permitindo tratamento direcionado e redução de complicações.
Diagnóstico laboratorial
O diagnóstico das infecções fúngicas combina métodos tradicionais e modernos. A microscopia direta permite observar estruturas fúngicas nas amostras clínicas, fornecendo indicação inicial do agente. A cultura fúngica possibilita o isolamento e a identificação detalhada do organismo, bem como testes de susceptibilidade antifúngica.
Testes sorológicos detectam antígenos ou anticorpos específicos e são particularmente úteis em infecções sistêmicas ou invasivas, enquanto técnicas de biologia molecular, como PCR e sequenciamento genético, oferecem alta sensibilidade e rapidez, mesmo em casos complexos ou em pacientes imunossuprimidos.
Além disso, a integração de múltiplos métodos diagnósticos aumenta a precisão, reduz falsos negativos e permite monitoramento contínuo da resposta ao tratamento.
Tratamento e manejo clínico
O tratamento depende do tipo de fungo, localização da infecção, gravidade do quadro e fatores individuais do paciente. Entre os antifúngicos mais utilizados estão azóis, polienos e equinocandinas, que podem ser aplicados isoladamente ou em combinações estratégicas.
O monitoramento laboratorial durante o tratamento é fundamental para avaliar a eficácia da terapia, ajustar doses e detectar resistência emergente. Em infecções graves, a combinação de abordagens terapêuticas, incluindo antifúngicos sistêmicos e medidas de suporte clínico, é essencial para a redução de morbidade e mortalidade.
As infecções fúngicas representam um campo complexo e dinâmico da microbiologia clínica. A precisão no diagnóstico, aliada ao conhecimento detalhado dos agentes, suas características e susceptibilidades, é crucial para um manejo eficaz. A integração de métodos laboratoriais tradicionais e modernos proporciona maior confiabilidade, rapidez e assertividade na escolha do tratamento, contribuindo significativamente para o sucesso clínico.
Com os avanços contínuos em técnicas diagnósticas e compreensão do comportamento dos fungos patogênicos, é possível identificar infecções precocemente, reduzir complicações e otimizar resultados terapêuticos, reforçando a importância da microbiologia clínica na prática moderna.
Domine a microbiologia clínica na prática. Transforme seu conhecimento em expertise aplicada em laboratórios clínicos e investigação de infecções com a Pós-graduação em Microbiologia Clínica da Cursau Educação. Saiba mais